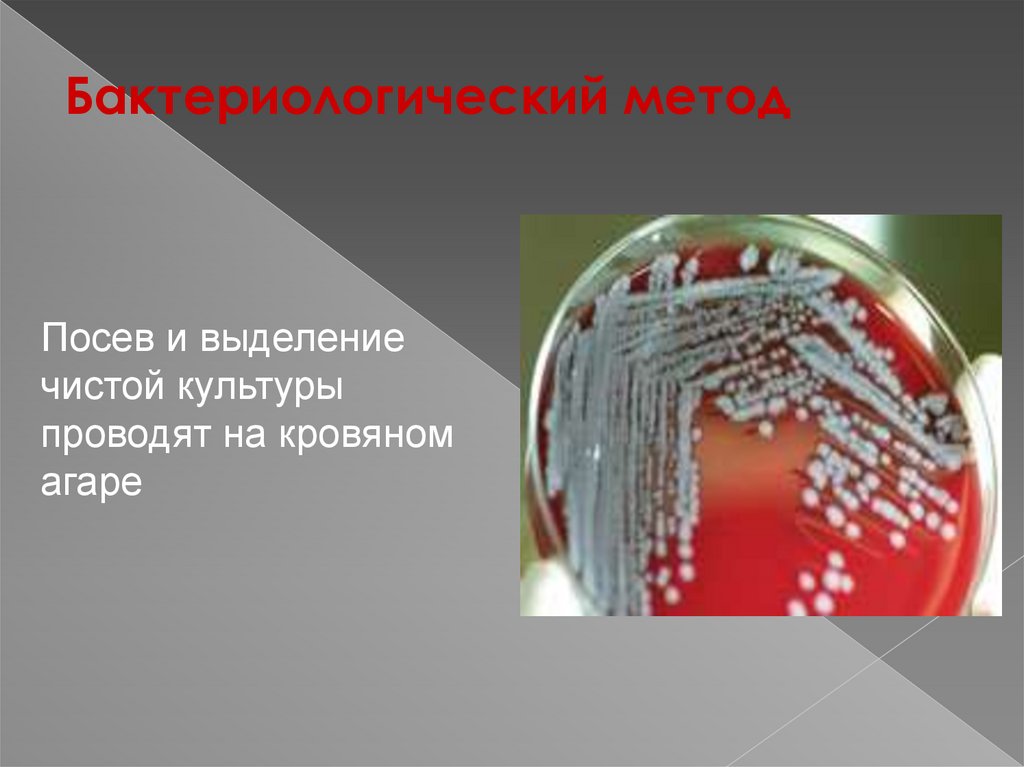

Similar presentations:
Сибирская язва
1. Сибирская язва
2.
СИБИРСКАЯ ЯЗВАСибирская язва – острая зоонозная инфекция,
протекающая с тяжелой интоксикацией, серозногеморрагическим воспалением кожи и
лимфоузлов, вовлечением внутренних органов,
развитием сепсиса.
3.
Таксономическое положениевозбудителя сибирской язвы
Семейство
Bacillaceae
Род Bacillus
Вид Bacillus anthracis
- B.anthracis
4. Этиология
крупная гр(-) палочка, образует споры икапсулу. Содержит соматический и
капсульный антиген, способна выделять
экзотоксин. Вегетативные формы
сибиреязвенной палочки быстро гибнут
без доступа воздуха, при нагревании и
действии обычно дезинфицирующих
средств. Споры намного устойчивее,
сохраняются в почве десятилетиями.
Погибают при автоклавировании,
действии активированных растворов
хлорамина, формальдегида, перекиси
водорода.
5.
B.аnthracis в органах (окраскапо Граму) - видна капсула
6. Эпидемиология
Источник инфекции - домашние животные (крупныйрогатый скот, лошади, овцы, козы, верблюды, свиньи).
Пути передачи инфекции - чаще контактный, реже алиментарный, воздушно-пылевой и трансмиссивный.
Заражение происходит при уходе за больным
животным, убое скота и разделке мяса, при контакте с
продуктами животноводства (шкура, кожа, меховые
изделия). Возможно заражение через почву.
Поражаются в основном открытые участки кожи.
Восприимчивость зависит от пути заражения и величины
инфицирующей дозы.
7. Патогенез
Входными воротами инфекции чаще всего являетсяповрежденная кожа. Редко слизистые оболочки
дыхательных путей и желудочно-кишечного тракта.
На месте внедрения возбудителя возникает
сибиреязвенный карбункул. Его возникновение связано с
выделением экзотоксина, который вызывает нарушения
микроциркуляции, отек и коагуляционный некроз.
Карбункул имеет вид очага серозно-геморрагического
воспаления, окруженного зоной отека с увеличением
регионарных лимфатических узлов.
Бактериемия и токсинемия могут провести к развитию
инфекционно-токсического шока.
8.
9.
10.
11.
12.
13.
14.
15.
16.
17.
18.
19.
20. Клиника
Инкубационный период от нескольких часов до 8 дней (чаще 2-3 дня).- Кожная форма. Обычно появляется одиночный карбункул, но иногда их количество
достигает 10-20 и более. На месте входных ворот инфекции последовательно
развивается пятно, папула, везикула, язва. По периферии язвочки развивается
воспалительный валик. Одновременно с этим вокруг язвочки развивается отек и
регионарный лимфаденит. К моменту образования язвочки появляется лихорадка,
которая продолжается в течение 5-7 дней, общая слабость, разбитость, головная
боль, адинамия. Местные изменения в области поражения нарастают примерно в
течение тех же сроков, что и лихорадка, а затем начинается обратное развитие:
сначала снижается температура тела, прекращается отдаление серозной
жидкости из зоны некроза, начинается уменьшение (до полного исчезновения)
отека, а на месте некроза постепенно формируется струп. На 10-14-й день струп
отторгается, образуется язва с гранулирующим дном И умеренным гнойным
отделяемым с последующим рубцеванием.
- Легочная форма сибирской язвы начинается остро, протекает тяжело. Проявляется
болью в груди, одышкой, цианозом, тахикардией (до 120-140 в 1 мин), кашлем с
отделением пенистой кровянистой мокроты. Температура тела быстро достигает
высоких цифр (40° С и выше), АД снижается.
- Кишечная форма сибирской язвы характеризуется общей интоксикацией,
повышением температуры тела, болью в эпигастральной области, поносом и
рвотой. Живот вздут, резко болезнен при пальпации, нередко имеются признаки
раздражения брюшины. В рвотных массах и выделениях из кишечника появляется
примесь крови.
21. Диагностика
Значение имеют клинические иэпидемиологические данные.
Лабораторная диагностика включает
бактериоскопический и бактериологический
методы, ИФА. Материалом является
содержимое везикул и карбункулов, при
септической форме - кровь, рвотные и каловые
массы. Применяют также кожно-аллергическую
пробу с антраксином. Аллерген вводят
подкожно в дозе 0,1 мл. Проба положительна
после 5-го дня болезни.
22.
Методиммунофлюоресценции –
экспресс-метод
23.
Бактериологический методПосев и выделение
чистой культуры
проводят на кровяном
агаре
24.
Споры B.anthracis - окраскапростым методом и по
Ожешки
25. Диф. диагностика.
Сибирскую язвудифференцируют с
сапом, банальными
фурункулами и
карбункулами,
чумой, туляремией,
рожей, сепсисом
другой этиологии.
26. Лечение
При легких формах болезни назначают пенициллин в дозе200-300 тыс. ЕД 6-8 раз в сутки в течение 5-7 дней. При тяжелых
формах болезни эффективны цефалоспорины по 4,0-6,0 г в
сутки, левомицетина сукцинат натрия по 3,0-4,0 г в сутки,
гентамицин по 240-320 мг в сутки. Лучшие результаты дает
лечение антибиотиками в сочетании со специфическим
противоязвенным иммуноглобулином в дозе 20-75 мл в/м.
При тяжелых формах сибирской язвы для выведения больного
из ИТШ требуется интенсивная патогенетическая терапия:
коллоидные и кристаллоидные растворы, плазма, альбумин.
Назначают глюкокортикостероиды.
27.
Специфическая профилактикаДля активной профилактики
сибирской язвы применяются:
- Вакцина живая СТИ,
представляющая собой споры
бескапсульного штамма
B.anthracis
- Вакцина комбинированная, в
состав ее входит живая
вакцина СТИ и протективный
антиген B.anthracis
28.
ИммунитетПосле перенесенной сибирской язвы
развивается стойкий антимикробный
и антитоксический иммунитет

medicine
medicine








